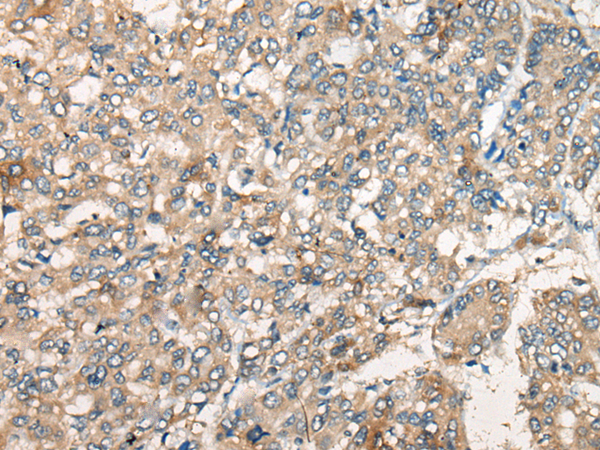

中文名稱: 兔抗PPARG多克隆抗體
英文名稱: Anti-PPARG rabbit polyclonal antibody
別 名: GLM1; CIMT1; NR1C3; PPARG1; PPARG2; PPARgamma
相關類別: 一抗
儲 存: 冷凍(-20℃)
宿 主: Rabbit
抗 原: PPARG
反應種屬: Human, Mouse, Rat
標 記 物: Unconjugate
克隆類型: rabbit polyclonal
技術規格
|
Background: |
This gene encodes a member of the peroxisome proliferator-activated receptor (PPAR) subfamily of nuclear receptors. PPARs form heterodimers with retinoid X receptors (RXRs) and these heterodimers regulate transcription of various genes. Three subtypes of PPARs are known: PPAR-alpha, PPAR-delta, and PPAR-gamma. The protein encoded by this gene is PPAR-gamma and is a regulator of adipocyte differentiation. Additionally, PPAR-gamma has been implicated in the pathology of numerous diseases including obesity, diabetes, atherosclerosis and cancer. Alternatively spliced transcript variants that encode different isoforms have been described. |
|
Applications: |
ELISA, WB, IHC |
|
Name of antibody: |
PPARG |
|
Immunogen: |
Synthetic peptide of human PPARG |
|
Full name: |
peroxisome proliferator activated receptor gamma |
|
Synonyms: |
GLM1; CIMT1; NR1C3; PPARG1; PPARG2; PPARgamma |
|
SwissProt: |
P37231 |
|
ELISA Recommended dilution: |
5000-10000 |
|
IHC positive control: |
Human liver cancer and human breast cancer |
|
IHC Recommend dilution: |
20-100 |

購物車
幫助
021-54845833/15800441009
